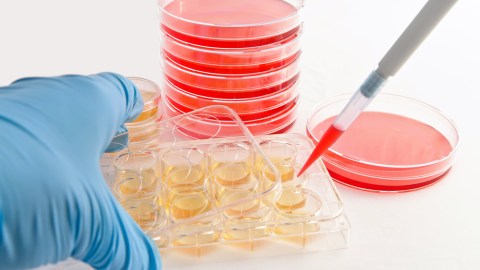
Investigadores expusieron células de  ratones recién nacidos a un ambiente más ácido al que están acostumbrados y las convirtió en células madre.

Fiscal de Nueva York demanda a doctor y clínica de lujo por fraude con células madre
Se les acusa de publicidad engañosa a pacientes vulnerables
Investigadores expusieron células de ratones recién nacidos a un ambiente más ácido al que están acostumbrados y las convirtió en células madre. Crédito: Archivo / Shutterstock
La fiscal general del estado, Letitia James, presentó una demanda ayer contra un médico de Manhattan y su clínica, alegando falsas afirmaciones sobre sus costosos tratamientos con células madre.
La demanda en la Corte Suprema de Manhattan alega que el Dr. Joel Singer, quien administra la clínica “Park Avenue Stem Cell” (PASC), cobra $3,995 dólares por las inyecciones de células madre de riesgo no aprobadas por la Administración de Drogas y Alimentos (FDA), utilizando la propia grasa de los pacientes, informó New York Post.
En su sitio web y en las publicaciones de las redes sociales, la clínica ha “representado sistemáticamente, directa e implícitamente, que los procedimientos de células madre de PASC se pueden usar para “tratar” o “mejorar” eficazmente una amplia gama de afecciones” urológicas, neurológicas, cardíacas, pulmonares, autoinmunes y ortopedia.
“Aunque actualmente no existe una evidencia científica adecuada de que estos tratamientos serán efectivos; de hecho, podrían ser perjudiciales “, alega la demanda.
La clínica lleva falsamente a los pacientes a creer que los tratamientos están respaldados científicamente y que está participando en estudios clínicos, según los documentos judiciales.
Tampoco revela a los pacientes que le dio a la estrella de radio Curtis Sliwa y a Darrel Reid, ex jugador de los Denver Broncos NFL, tratamientos gratuitos a cambio de sus testimonios en video, publicados en su portal y en Facebook, diciendo qué tan bien les funcionaron los tratamientos.
Si bien existe un aclaratoria en el sitio web sobre cómo varían los resultados, esto está en letra pequeña en un lugar difícil de encontrar, dicen los documentos de la corte.
La fiscalía de NY quiere impedir que la práctica haga más publicidad engañosa y también busca daños de $5 mil dólares por anuncio falso y otros $2 mil en restitución a 300 pacientes que se sometieron a tratamientos con células madre.
“Engañar a los consumidores vulnerables que están desesperados por encontrar un tratamiento para afecciones médicas graves y dolorosas es inaceptable, ilegal e inmoral”, dijo James en un comunicado.
También dijo que PASC está afiliada y sigue los protocolos de una compañía de California llamada “Cell Surgical Network” que fue demandada el año pasado por la FDA por administrar malos tratamientos con células madre.
Ni la clínica y ni el doctor Singer estuvieron disponibles para comentarios, destacó New York Post.